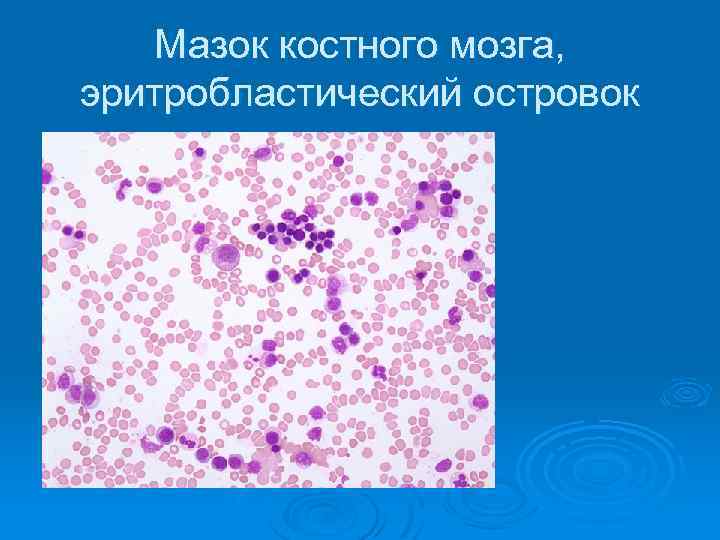

Органы кроветворения.ppt
- Количество слайдов: 89
 Кроветворные органы
Кроветворные органы
 Органы кроветворения и иммуногенеза Ø -это совокупность органов, обеспечивающих физиологическую регенерацию элементов крови; Ø -поддерживающих гомеостаз системы крови и иммунокомпетентных клеток; Ø -способны депонировать кровь и лимфу
Органы кроветворения и иммуногенеза Ø -это совокупность органов, обеспечивающих физиологическую регенерацию элементов крови; Ø -поддерживающих гомеостаз системы крови и иммунокомпетентных клеток; Ø -способны депонировать кровь и лимфу
 Органы кроветворения Ø -различают центральные кроветворные органы – костный мозг и тимус (антигеннезависимое развитие элементов крови); Ø -периферические органы –селезенка, лимфатические и гемолифатические узлы (антигензависимое развитие)
Органы кроветворения Ø -различают центральные кроветворные органы – костный мозг и тимус (антигеннезависимое развитие элементов крови); Ø -периферические органы –селезенка, лимфатические и гемолифатические узлы (антигензависимое развитие)
 Гемоцитопоэз Ø - развитие элементов крови: Ø Различают эмбриональный гемопоэз – Ø -кровь формируется как ткань; Ø - постэмбриональный гемопоэз – Ø -процесс физиологической регенерации крови
Гемоцитопоэз Ø - развитие элементов крови: Ø Различают эмбриональный гемопоэз – Ø -кровь формируется как ткань; Ø - постэмбриональный гемопоэз – Ø -процесс физиологической регенерации крови
 Эмбриональный гемопоэз Ø - выделяют 3 этапа: Ø -желточный Ø -гепатолиенальный Ø -медуллярный (костномозговой)
Эмбриональный гемопоэз Ø - выделяют 3 этапа: Ø -желточный Ø -гепатолиенальный Ø -медуллярный (костномозговой)
 Желточный этап
Желточный этап
 Постэмбриональный гемопоэз - клеточное обновление Ø Общепринята унитарная теория кроветворения Ø Источник образования всех форменных элементов крови – единая популяция полипотентных стволовых клеток (СКК)
Постэмбриональный гемопоэз - клеточное обновление Ø Общепринята унитарная теория кроветворения Ø Источник образования всех форменных элементов крови – единая популяция полипотентных стволовых клеток (СКК)

 Мегакариоцит
Мегакариоцит
 Центральные органы кроветворения Ø Костный мозг – центральный универсальный кроветворный орган; Ø – содержит самоподдерживающуюся популяцию стволовых клеток из которых образуются эритроциты, гранулоциты, Ø тромбоциты, В-лимфоциты и предшественники Т-лимфоцитов
Центральные органы кроветворения Ø Костный мозг – центральный универсальный кроветворный орган; Ø – содержит самоподдерживающуюся популяцию стволовых клеток из которых образуются эритроциты, гранулоциты, Ø тромбоциты, В-лимфоциты и предшественники Т-лимфоцитов
 Костный мозг Ø У взрослого человека различают Ø - красный Ø - желтый костный мозг; Ø Строма костного мозга – ретикулярная ткань
Костный мозг Ø У взрослого человека различают Ø - красный Ø - желтый костный мозг; Ø Строма костного мозга – ретикулярная ткань
 Локализация костного мозга
Локализация костного мозга
 Срез костного мозга
Срез костного мозга
 Срез костного мозга
Срез костного мозга
 Эритробластические клетки Ø -полихроматофильные эритробласты, Ø -оксифильные эритробласты, Ø - ретикулоциты, Ø - зрелые эритроциты
Эритробластические клетки Ø -полихроматофильные эритробласты, Ø -оксифильные эритробласты, Ø - ретикулоциты, Ø - зрелые эритроциты
Мазок костного мозга, эритробластический островок
Мазок костного мозга, эритробластический островок
 Гранулоцитопоэтические клетки Ø - промиелоциты, Ø - метамиелоциты, Ø - палочкоядерные гранулоциты, Ø - зрелые гранулоциты (сегментоядерные)
Гранулоцитопоэтические клетки Ø - промиелоциты, Ø - метамиелоциты, Ø - палочкоядерные гранулоциты, Ø - зрелые гранулоциты (сегментоядерные)
 Мазок костного мозга
Мазок костного мозга
 Мегакариоциты
Мегакариоциты
 Мегакариоцит- гигантская клетка костного мозга
Мегакариоцит- гигантская клетка костного мозга
 Тромбоцитопоэз
Тромбоцитопоэз
 Тимус - вилочковая железа Ø - центральный орган лимфо- и иммунопоэза; Ø - в тимусе происходит антигеннезависимое развитие Ø Т-лимфоцитов
Тимус - вилочковая железа Ø - центральный орган лимфо- и иммунопоэза; Ø - в тимусе происходит антигеннезависимое развитие Ø Т-лимфоцитов
 Функции тимуса Ø -образование Т-лимфоцитов (тимоциты) Ø - синтез гормона тимозина (регулирует дифференцировку лимфоцитов); Ø - синтез инсулиноподобного фактора (снижает сахар крови); Ø - кальцитониноподобный фактор (снижает уровень кальция и фосфора); Ø -вырабатывает фактор роста
Функции тимуса Ø -образование Т-лимфоцитов (тимоциты) Ø - синтез гормона тимозина (регулирует дифференцировку лимфоцитов); Ø - синтез инсулиноподобного фактора (снижает сахар крови); Ø - кальцитониноподобный фактор (снижает уровень кальция и фосфора); Ø -вырабатывает фактор роста
 Развитие тимуса Ø - в конце 1 мес. эмбриогенеза, Ø - из эпителия глоточной кишки на уровне III – IY жаберных карманов; Ø - первые лимфоциты появляются на Ø 7 -ой неделе; Ø - корковое и мозговое вещество определяется в конце 3 мес
Развитие тимуса Ø - в конце 1 мес. эмбриогенеза, Ø - из эпителия глоточной кишки на уровне III – IY жаберных карманов; Ø - первые лимфоциты появляются на Ø 7 -ой неделе; Ø - корковое и мозговое вещество определяется в конце 3 мес
 Развитие тимуса Ø - к 6 мес. заканчивается формирование Ø -15 -17 сутки после рождения –массовое выселение Т-лимфоцитов, Ø - к достижению половой зрелости – максимальное развитие, Ø - до 20 лет – стабилизация массы, Ø - после 20 лет- инволюция Ø - к 30 годам функция тимуса минимальна
Развитие тимуса Ø - к 6 мес. заканчивается формирование Ø -15 -17 сутки после рождения –массовое выселение Т-лимфоцитов, Ø - к достижению половой зрелости – максимальное развитие, Ø - до 20 лет – стабилизация массы, Ø - после 20 лет- инволюция Ø - к 30 годам функция тимуса минимальна
 Тимус Ø самый таинственный орган человеческого организма — вилочковая железа
Тимус Ø самый таинственный орган человеческого организма — вилочковая железа
 Строение тимуса
Строение тимуса
 Строение тимуса Ø - дольчатое строение; Ø - в каждой дольке выделяют корковое и мозговое вещество, Ø строма тимуса – видоизмененные лимфоциты – (эпителиоретикулярные клетки);
Строение тимуса Ø - дольчатое строение; Ø - в каждой дольке выделяют корковое и мозговое вещество, Ø строма тимуса – видоизмененные лимфоциты – (эпителиоретикулярные клетки);
 Дольчатое строение
Дольчатое строение
 Долька тимуса
Долька тимуса
 Корковое вещество тимуса Ø -заселяют лимфобласты из костного мозга; Ø - пролиферируют под воздействием тимозина – Аg-независимые лимфоциты; Ø -каждые 6 -9 час- новые генерации Т-л; Ø -селекция лимфоцитов: отбираются Т-л резистентные к собственным белкам
Корковое вещество тимуса Ø -заселяют лимфобласты из костного мозга; Ø - пролиферируют под воздействием тимозина – Аg-независимые лимфоциты; Ø -каждые 6 -9 час- новые генерации Т-л; Ø -селекция лимфоцитов: отбираются Т-л резистентные к собственным белкам
 Мозговое вещество Ø - рециркулирующий пул Т-лимфоцитов
Мозговое вещество Ø - рециркулирующий пул Т-лимфоцитов
 Тельца Гассаля
Тельца Гассаля
 Тельца Гассаля
Тельца Гассаля
 Гематотимусный барьер
Гематотимусный барьер
 Гематотимусный барьер Ø - предохраняет пролиферирующие лимфоциты от избытка антигенов
Гематотимусный барьер Ø - предохраняет пролиферирующие лимфоциты от избытка антигенов
 Инволюция тимуса Ø - возрастная – мах. относительный размер в первые 2 года жизни, Ø Акцидентальная (временная, быстрая)- Ø -возникает при травмах, интоксикации, голодании, стрессах
Инволюция тимуса Ø - возрастная – мах. относительный размер в первые 2 года жизни, Ø Акцидентальная (временная, быстрая)- Ø -возникает при травмах, интоксикации, голодании, стрессах
 Периферические органы иммуногенеза Ø -под влиянием Аg обеспечивают Аg- зависимую дифференцировку лимфоцитов; Ø -образование иммунных клеток- эффекторов (Т-kill, T-help, T-suppress) и клеток- памяти
Периферические органы иммуногенеза Ø -под влиянием Аg обеспечивают Аg- зависимую дифференцировку лимфоцитов; Ø -образование иммунных клеток- эффекторов (Т-kill, T-help, T-suppress) и клеток- памяти
 Лимфатические узлы
Лимфатические узлы
 Лимфатические узлы Ø -располагаются по ходу лимфатических сосудов; Ø -их кол-во – 400; Ø -общий вес – до 1 кг. ; Ø -форма округлая или овальная,
Лимфатические узлы Ø -располагаются по ходу лимфатических сосудов; Ø -их кол-во – 400; Ø -общий вес – до 1 кг. ; Ø -форма округлая или овальная,
 Лимфатический узел Ø -покрыт соединительнотканной капсулой; Ø - с вогнутой стороны – ворота узла; Ø - в ворота входят артерии, выходят вены и выносящие лим. сосуды; Ø - приносящие лимфатические сосуды входят с выпуклой стороны.
Лимфатический узел Ø -покрыт соединительнотканной капсулой; Ø - с вогнутой стороны – ворота узла; Ø - в ворота входят артерии, выходят вены и выносящие лим. сосуды; Ø - приносящие лимфатические сосуды входят с выпуклой стороны.
 Лимфатический узел - схема
Лимфатический узел - схема
 На срезе лимфоузла различают Ø - темное корковое вещество: Ø -кортикальная зона, Ø -паракартикальная зона; Ø - светлое мозговое вещество; Ø -строма узла – ретикулярная ткань
На срезе лимфоузла различают Ø - темное корковое вещество: Ø -кортикальная зона, Ø -паракартикальная зона; Ø - светлое мозговое вещество; Ø -строма узла – ретикулярная ткань
 Строение лимфатического узла
Строение лимфатического узла
 Корковое и мозговое вещество
Корковое и мозговое вещество
 Кортикальная зона Ø - под капсулой - определяются лимфатические фолликулы; Ø - зона В-лимфоцитов
Кортикальная зона Ø - под капсулой - определяются лимфатические фолликулы; Ø - зона В-лимфоцитов
 Лимфатические фолликулы
Лимфатические фолликулы
 Лимфоидные фолликулы Ø - проходят 4 стадии развития: Ø -начальная стадия, Ø -формирование центра размножения, Ø - формирование мантии, Ø - стадия относительного покоя
Лимфоидные фолликулы Ø - проходят 4 стадии развития: Ø -начальная стадия, Ø -формирование центра размножения, Ø - формирование мантии, Ø - стадия относительного покоя
 В фолликулах выделяют: Ø - центральная часть- реактивный центр (центр размножения В-лимфобластов), Ø -периферическая часть – мантийная зона; Ø - содержат лимфоциты, лимфобласты, дендритные клетки, макрофаги
В фолликулах выделяют: Ø - центральная часть- реактивный центр (центр размножения В-лимфобластов), Ø -периферическая часть – мантийная зона; Ø - содержат лимфоциты, лимфобласты, дендритные клетки, макрофаги
 Лимфатические фолликулы узелки
Лимфатические фолликулы узелки
 Паракортикальная зона Ø - зона пролиферации и созревания Т- лимфоцитов; Ø - образование клеток-эффекторов; Ø -клетки микроокружения – интердигитирующие клетки – стимулируют развитие лимфоцитов
Паракортикальная зона Ø - зона пролиферации и созревания Т- лимфоцитов; Ø - образование клеток-эффекторов; Ø -клетки микроокружения – интердигитирующие клетки – стимулируют развитие лимфоцитов
 Зоны лимфатического узла
Зоны лимфатического узла
 Мозговое вещество Ø -мозговые тяжи (В-лимфоциты, плазмоциты, макрофаги) – пролиферация и созревание плазмоцитов; Ø - мозговые синусы- тонкостенные сосуды, покрыты ретикулоэндотелиальными клетками
Мозговое вещество Ø -мозговые тяжи (В-лимфоциты, плазмоциты, макрофаги) – пролиферация и созревание плазмоцитов; Ø - мозговые синусы- тонкостенные сосуды, покрыты ретикулоэндотелиальными клетками
 Мозговое вещество
Мозговое вещество
 Синусы лимфатического узла Ø -тонкостенные сосуды, выстланы ретикулоэндотелиальными клетками; Ø Различают: краевой синус; Ø -промежуточный корковый; Ø -промежуточный мозговой; Ø -воротный синус
Синусы лимфатического узла Ø -тонкостенные сосуды, выстланы ретикулоэндотелиальными клетками; Ø Различают: краевой синус; Ø -промежуточный корковый; Ø -промежуточный мозговой; Ø -воротный синус
 Синусы лимфатического узла
Синусы лимфатического узла
 Селезенка Ø -непарный, паренхиматозный, периферический орган кроветворной и иммунной системы; Ø Функции: - кроветворение, Ø - иммунная; Ø -депонирование крови; Ø - синтез активных веществ
Селезенка Ø -непарный, паренхиматозный, периферический орган кроветворной и иммунной системы; Ø Функции: - кроветворение, Ø - иммунная; Ø -депонирование крови; Ø - синтез активных веществ

 Развитие селезенки Ø - закладывается на 5 нед; Ø - на 12 нед заселяется В-лимфоцитами; Ø - на 5 -мес. формируются фолликулы, Ø а миелопоэз достигает максимума; Ø - на 6 мес формируется красная пульпа
Развитие селезенки Ø - закладывается на 5 нед; Ø - на 12 нед заселяется В-лимфоцитами; Ø - на 5 -мес. формируются фолликулы, Ø а миелопоэз достигает максимума; Ø - на 6 мес формируется красная пульпа
 Васкуляризация селезенки Ø -в ворота входит селезеночная артерия; Ø - сегментарные артерии; Ø - трабекулярные; Ø -пульпарные; Ø -центральная (фолликулярная) артериола; Ø -кисточковые артериолы; Ø -гемокапилляры;
Васкуляризация селезенки Ø -в ворота входит селезеночная артерия; Ø - сегментарные артерии; Ø - трабекулярные; Ø -пульпарные; Ø -центральная (фолликулярная) артериола; Ø -кисточковые артериолы; Ø -гемокапилляры;
 Типы кровообращения селезенки Ø - гемокапилляры впадают в венозные синусы – закрытое кровообращение; Ø -гемокапилляры открываются в красную пульпу – открытое кровообращение
Типы кровообращения селезенки Ø - гемокапилляры впадают в венозные синусы – закрытое кровообращение; Ø -гемокапилляры открываются в красную пульпу – открытое кровообращение

 Венозная система Ø -венозные синусы; Ø -трабекулярные вены (безмышечные); Ø -сегментарные вены; Ø -воротная вена
Венозная система Ø -венозные синусы; Ø -трабекулярные вены (безмышечные); Ø -сегментарные вены; Ø -воротная вена
 Строение селезенки Ø -покрыта соед. тканной капсулой; Ø - строма - ретикулярная Ø -выделяют белую пульпу и красную пульпу
Строение селезенки Ø -покрыта соед. тканной капсулой; Ø - строма - ретикулярная Ø -выделяют белую пульпу и красную пульпу
 Особенности капсулы селезенки Ø - плотная волокнистая ткань; Ø -покрыта мезотелием Ø -содержит гладкие миоциты; Ø -от капсулы отходят трабекулы; Ø Капсула и трабекулы образуют опорно- сократительный аппарат селезенки
Особенности капсулы селезенки Ø - плотная волокнистая ткань; Ø -покрыта мезотелием Ø -содержит гладкие миоциты; Ø -от капсулы отходят трабекулы; Ø Капсула и трабекулы образуют опорно- сократительный аппарат селезенки
 Строение селезенки
Строение селезенки

 Белая пульпа Ø - это совокупность лимфоидной ткани в адвентиции пульпарных артерий; Ø - в фолликуле различают 4 зоны: -периартериальная, -герминативный центр, -мантийная, -краевая
Белая пульпа Ø - это совокупность лимфоидной ткани в адвентиции пульпарных артерий; Ø - в фолликуле различают 4 зоны: -периартериальная, -герминативный центр, -мантийная, -краевая

 Периартериальная зона фолликула Ø - состоит из Т-лимфоцитов – тимус-зависимая; интердигитирующие клетки – Аg-представляющие -
Периартериальная зона фолликула Ø - состоит из Т-лимфоцитов – тимус-зависимая; интердигитирующие клетки – Аg-представляющие -
 Центральная артериола
Центральная артериола
 Герминативный центр Ø - центр размножения В-лимфобластов; Ø - пролиферирующие В-лимфоциты, Ø - макрофаги,
Герминативный центр Ø - центр размножения В-лимфобластов; Ø - пролиферирующие В-лимфоциты, Ø - макрофаги,
 Мантийный слой Ø -слои из Т- и В-лимфоцитов, Ø -макрофаги, Ø -Аg –представляющие клетки, Ø - NK-лимфоциты
Мантийный слой Ø -слои из Т- и В-лимфоцитов, Ø -макрофаги, Ø -Аg –представляющие клетки, Ø - NK-лимфоциты
 Маргинальная зона (краевая) Ø -переходная зона к красной пульпе; Ø -окружена синусоидными капиллярами; Ø - В-лимфоциты трансформируются в плазматические клетки
Маргинальная зона (краевая) Ø -переходная зона к красной пульпе; Ø -окружена синусоидными капиллярами; Ø - В-лимфоциты трансформируются в плазматические клетки
 Зоны лимфотического фолликула
Зоны лимфотического фолликула
 Красная пульпа Ø - элементы крови; Ø -капилляры и венозные синусы; Ø -клетки ретикулярной стромы. Ø В красной пульпе идет элиминация эритроцитов макрофагами; Ø Завершается плазмоцитогенез
Красная пульпа Ø - элементы крови; Ø -капилляры и венозные синусы; Ø -клетки ретикулярной стромы. Ø В красной пульпе идет элиминация эритроцитов макрофагами; Ø Завершается плазмоцитогенез

 Красная пульпа
Красная пульпа
 Ø Спасибо за внимание
Ø Спасибо за внимание








 Мегакариоцит
Мегакариоцит



